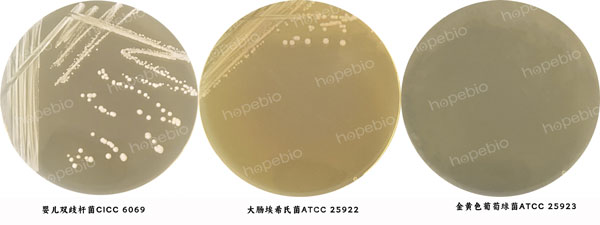

海博微信公众号
海博微信公众号
 海博天猫旗舰店
海博天猫旗舰店


 海博微信公众号
海博微信公众号
 海博天猫旗舰店
海博天猫旗舰店




一、产品用途及原理
用途:本培养基用于双歧杆菌的分离培养。
原理:蛋白胨、肝浸粉、牛肉浸粉、酵母浸粉、胰酪蛋白胨为微生物的生长提供氮源、维生素和生长因子;可溶性淀粉、葡萄糖为微生物生长提供碳源;氯化钠维持均衡的渗透压;磷酸氢二钾、磷酸二氢钾可调节培养基的酸碱度和离子平衡;FeSO4•7H2O、MnSO4为微生物的生长提供生长因子;L-半胱氨酸为还原剂,辅助培养基维持厌氧环境,有利于厌氧菌的生长;吐温80可促进双歧杆菌的生长并能中和一些有毒成分;琼脂为培养基的凝固剂。
二、培养基配方(g/L)
|
蛋白胨 |
10.0 |
|
肝浸粉 |
5.0 |
|
牛肉浸粉 |
3.0 |
|
酵母浸粉 |
5.0 |
|
胰酪蛋白胨 |
8.0 |
|
可溶性淀粉 |
0.5 |
|
氯化钠 |
1.0 |
|
磷酸氢二钾 |
1.0 |
|
磷酸二氢钾 |
1.0 |
|
葡萄糖 |
10.0 |
|
FeSO4·7H2O |
0.01 |
|
MnSO4 |
0.005 |
|
L-半胱氨酸 |
0.5 |
|
琼脂 |
20.0 |
|
pH值7.2±0.1(25℃) |
|
三、试验方法
1、称取本品68.9g,再吸取1mL吐温80,加热溶解于1000mL蒸馏水中,116℃高压灭菌30分钟,冷却至50℃-55℃时,倾入无菌平皿,备用。
2、将质控菌株划线接种到培养基上。
3、放置于36℃±1℃厌氧培养24h-48h。
四、结果观察
接种以下质控菌株,放置于36℃±1℃厌氧培养24h-48h。培养结果如图1。
|
质控菌株 |
菌株编号 |
生长情况 |
其它特征 |
|
婴儿双歧杆菌 |
CICC 6069 |
+++ |
生长良好 |
|
大肠埃希氏菌 |
ATCC 25922 |
+ |
/ |
|
金黄色葡萄球菌 |
ATCC 25923 |
- |
/ |
图1 双歧杆菌BS培养基的微生物质控结果
五、注意事项
培养基中有少量淀粉、硫酸亚铁、硫酸锰,灭菌后可能出现少量沉淀。
相关产品:
注:本文属海博生物原创,未经允许不得转载。
上一篇:马铃薯葡萄糖琼脂的使用方法和现象



